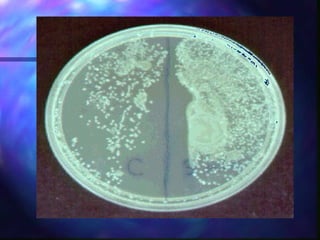

Este documento presenta un resumen de un curso para manipuladores de alimentos. Explica que las causas más comunes de intoxicación alimentaria son microbios patógenos como estafilococos, clostridios y salmonela, los cuales se propagan fácilmente a través de las manos de los manipuladores de alimentos. También destaca la importancia de lavarse bien las manos con agua, jabón y cepillo de uñas para prevenir la contaminación de los alimentos.